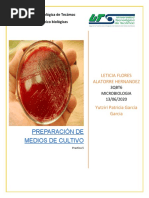

0% encontró este documento útil (1 voto)
2K vistas15 páginasLaboratorio 9 Ecometra
Este documento describe los pasos para realizar un control de calidad efectivo de los medios de cultivo utilizados en un laboratorio de microbiología de alimentos. Explica que es importante verificar la calidad de los medios para asegurar resultados confiables. Detalla los criterios mínimos que debe cumplir un programa de control de calidad, como realizar pruebas con cepas control para cada lote y desarrollar procedimientos estandarizados para la preparación y almacenamiento de los medios. También resume los pasos clave para la preparación correcta de los medios, como
Cargado por
arigatonaDerechos de autor
© Attribution Non-Commercial (BY-NC)
Nos tomamos en serio los derechos de los contenidos. Si sospechas que se trata de tu contenido, reclámalo aquí.
Formatos disponibles
Descarga como PDF, TXT o lee en línea desde Scribd
0% encontró este documento útil (1 voto)
2K vistas15 páginasLaboratorio 9 Ecometra
Este documento describe los pasos para realizar un control de calidad efectivo de los medios de cultivo utilizados en un laboratorio de microbiología de alimentos. Explica que es importante verificar la calidad de los medios para asegurar resultados confiables. Detalla los criterios mínimos que debe cumplir un programa de control de calidad, como realizar pruebas con cepas control para cada lote y desarrollar procedimientos estandarizados para la preparación y almacenamiento de los medios. También resume los pasos clave para la preparación correcta de los medios, como
Cargado por
arigatonaDerechos de autor
© Attribution Non-Commercial (BY-NC)
Nos tomamos en serio los derechos de los contenidos. Si sospechas que se trata de tu contenido, reclámalo aquí.
Formatos disponibles
Descarga como PDF, TXT o lee en línea desde Scribd